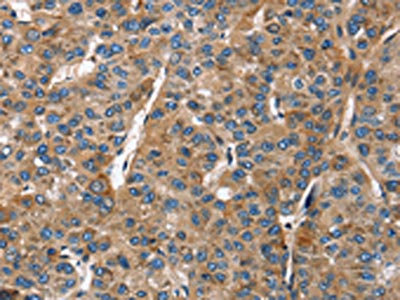

BGN Antibody
-
中文名稱:BGN兔多克隆抗體
-
貨號:CSB-PA157570
-
規格:¥1100
-
圖片:
-
The image on the left is immunohistochemistry of paraffin-embedded Human thyroid cancer tissue using CSB-PA157570(BGN Antibody) at dilution 1/50, on the right is treated with fusion protein. (Original magnification: ×200)
-
The image on the left is immunohistochemistry of paraffin-embedded Human liver cancer tissue using CSB-PA157570(BGN Antibody) at dilution 1/50, on the right is treated with fusion protein. (Original magnification: ×200)
-
-
其他:
產品詳情
-
Uniprot No.:
-
基因名:
-
別名:BGN antibody; Biglycan antibody; Biglycan proteoglycan antibody; Bone/cartilage proteoglycan I antibody; Dermatan sulphate proteoglycan I antibody; DSPG1 antibody; PG S1 antibody; PG-S1 antibody; PGI antibody; PGS1_HUMAN antibody; SEMDX antibody; SLRR1A antibody; Small leucine rich protein 1A antibody
-
宿主:Rabbit
-
反應種屬:Human,Mouse,Rat
-
免疫原:Fusion protein of Human BGN
-
免疫原種屬:Homo sapiens (Human)
-
標記方式:Non-conjugated
-
抗體亞型:IgG
-
純化方式:Antigen affinity purification
-
濃度:It differs from different batches. Please contact us to confirm it.
-
保存緩沖液:-20°C, pH7.4 PBS, 0.05% NaN3, 40% Glycerol
-
產品提供形式:Liquid
-
應用范圍:ELISA,IHC
-
推薦稀釋比:
Application Recommended Dilution ELISA 1:1000-1:5000 IHC 1:50-1:200 -
Protocols:
-
儲存條件:Upon receipt, store at -20°C or -80°C. Avoid repeated freeze.
-
貨期:Basically, we can dispatch the products out in 1-3 working days after receiving your orders. Delivery time maybe differs from different purchasing way or location, please kindly consult your local distributors for specific delivery time.
-
用途:For Research Use Only. Not for use in diagnostic or therapeutic procedures.
相關產品
靶點詳情
-
功能:May be involved in collagen fiber assembly.
-
基因功能參考文獻:
- The differential immunoexpression of perlecan and biglycan in these types of ameloblastomas suggests their participation in the developmental process of these tumors. PMID: 29921372
- TLR2 and BGN contribute to sterile inflammation and infertility in man. PMID: 27849015
- Results show that Biglycan expression was upregulated by DNA demethylation in tumour endothelial cells from myeloma. PMID: 27295191
- Elevated biglycan mRNA expression in adipose tissues of obese women PMID: 27465988
- sex-specific allele combinations of BGN, COL5A1, and DCN, as well as eight miRNA recognition sequences, were associated with altered susceptibility to anterior cruciate ligament ruptures PMID: 28927971
- high Bgn expression levels promote a more dense collagen architecture, leading to increased tissue stiffness. This increased tissue stiffness leads to higher integrin-beta1 expression on melanoma cells, which promotes their invasiveness. PMID: 28476030
- The expression of hBGN in the skeletal muscle of the treated mice was 1.34-fold higher than that of the native mouse Bgn (mBgn). The low transduction efficiency and improved motor functions suggest that biglycan expressed in a small number of muscle fibers was likely to have been secreted and anchored to the cell surface throughout the whole muscular fibers PMID: 27485975
- Results identified loss-of-function mutation in BGN gene in patients with an X-linked syndromic form of severe thoracic aortic aneurysms and dissections (TAAD) confirming BGN as causative gene in severe form of TAAD. PMID: 27632686
- After the first year of smoking abstinence the levels of BGN expression and carotid-femoral pulse wave velocity are significantly improved as compared to baseline. PMID: 28131044
- study reports a temporal relationship between altered placental biglycan expression and subsequent development of fetal growth restriction/small for gestational age. PMID: 28408374
- Quantitative polymerase chain reaction for messenger RNA expression from tissue specimens revealed significantly higher expression of Biglycan (p = 0.0008) and Lumican (p = 0.01) and lower expression of Decorin (p < 0.0001) in urothelial carcinoma of bladder PMID: 28459201
- Mutation in BGN gene is associated with X-Linked Spondyloepimetaphyseal Dysplasia. PMID: 27236923
- biglycan exerts an important role in cell proliferation, migration, invasion and apoptosis in colon cancer. PMID: 26459740
- BGN might play an important role on metastasis in human endometrial cancer and it might be a target marker for the molecular therapy of advanced and recurrence endometrial cancer. PMID: 26275380
- This study demonstrated that the small leucine-rich proteoglycan BGN accumulates in CADASIL and binds to NOTCH3. PMID: 25578324
- Biglycan may have a role in development of vascular damage in smokers PMID: 25463076
- BGN is a factor secreted by peritubular cells to modulate FGFR3c signaling and thus contributes to the regulation of spermatogonial maintenance PMID: 25260943
- The results suggest that regions within BGN is associated with ACL injury susceptibility and that genetic sequence variability within genes encoding proteoglycans may potentially modulate the ligament fibril properties. PMID: 24552666
- immunolocalization of decorin and biglycan in samples of first-trimester and term placentas, placenta accreta, invasive mole, and choriocarcinoma PMID: 24117774
- Biglycan modulates angiogenesis and bone formation during fracture healing. PMID: 24373744
- Data indicate that the biglycan (BGN) CC genotype was significantly over-represented in the control group versus the carpal tunnel syndrome (CTS) group. PMID: 25173489
- High expression of BGN in esophageal squamous cell carcinoma indicated aggressive tumor behaviors and predicted a worse clinical outcome. PMID: 24228112
- Mast cell chymase degrades the alarmins heat shock protein 70, biglycan, HMGB1, and interleukin-33 (IL-33) and limits danger-induced inflammation. PMID: 24257755
- ADAMTS-4 and its substrate biglycan are involved in tubulogenesis by endothelial cells PMID: 24051360
- The concentration of aggrecan, biglycan, and decorin was determined in six regions of the human supraspinatus tendon. PMID: 22329809
- Molecular haplotypes within the BGN promoter may contribute to the molecular basis of interindividually different transcriptional BGN regulation, possibly modulating the predisposition to cardiovascular disease-related phenotypes. PMID: 23393390
- pancreatic adenocarcinoma patients who presented PG-I expression in the extracellular matrix had worse prognosis compared to those who did not PMID: 23007878
- Extracellular soluble biglycan induces the expression of BMP-2 and ALP in human aortic valve interstitial cells primarily via TLR2 and contributes to the proosteogenic effect of oxLDL. PMID: 22982459
- Up-regulation of biglycan was significantly correlated with poor tumor differentiation, lymph node metastasis, and distant metastasis in colorectal cancer. PMID: 21879307
- Bgn inhibits the major properties of HER-2/neu-transformed cells, which is inversely modulated by the PKC signaling cascade. PMID: 22582394
- Data show that granzyme B (GrB) liberated TGF-beta1 from substrates decorin, biglycan and betaglycan. PMID: 22479366
- These findings suggested that biglycan is a novel tumor endothelial cell marker and a target for anti-angiogenic therapy PMID: 22374465
- Biglycan demonstrated distinctive localization relative to nodules within calcified aortic valves. PMID: 21185747
- Biglycan enhances ovalbumin-specific cross-priming by over 80% to histocompatibility class I-restricted T cells in both a Toll-like receptor (TLR)2- and TLR4-pathway-dependent manner in transgenic mice. PMID: 22095710
- findings demonstrate that Akt is a downstream signalling component of TGF-beta-mediated biglycan core protein synthesis but not glycosaminoglycan chain hyperelongation in vascular smooth muscle PMID: 21913799
- Data revealed a strong induction of several genes encoding components of the extracellular matrix, such as collagens, COMP, IGFBP5 and biglycan. PMID: 21029365
- This study demonstrates that elevated expression of biglycan may play an important role in the development and progression of gastric cancer, and could be further evaluated as a biomarker for predication of a poor clinical outcome. PMID: 21998129
- Immunoprecipitation analysis revealed that biglycan interacts with both the canonical Wnt ligand Wnt3a and the Wnt coreceptor low-density lipoprotein receptor-related protein 6 (LRP6), possibly via the formation of a trimeric complex. PMID: 21969569
- Biglycan and decorin reduced the proliferation of pre-adipocytes, partly by induction of apoptosis. Furthermore, the anti-proliferative capabilities of decorin and biglycan were nullified with removal of GAG side-chains. PMID: 21702857
- Differential expression of 4 out of 5 genes related to estrogen metabolism and action (ESR1, ESR2, PGR and BGN) was confirmed in endometriosis. PMID: 21397694
- Biglycan impinges on the expression of total epidermal growth factor receptor and possibly, on the cell-surface expression of the receptors, playing a critical role in the regulation of chondrocyte and pericellular matrix homeostasis. PMID: 20367117
- expressed decreased in fetal growth restriction placentae PMID: 20591478
- Data show that biglycan (BGN) induces of phospholipid transfer protein (PLTP) in aortic valve interstitial cells via stimulation of Toll-like receptor 2, so increased BGN in stenotic valves contributes to the production of PLTP via TLR 2. PMID: 20382708
- study shows (1) a detailed description of ectopic ossification (EO) formed by Bgn, Fmod or combined depletion, (2) the role of exercise in modulating EO and (3) that Bgn and Fmod are critical in controlling motor function. PMID: 19422643
- has two GAG chains and affinity to collagen PMID: 11979972
- BGN expression is regulated by TGFbeta1 in pancreatic tumor cells and has a role in controlling cell growth PMID: 12140283
- isoforms of biglycan have a smaller core protein substituted with smaller glycosaminoglycan chains, are N-glycosylated, which demonstrates that a lack in N-glycosylation is not the reason for a smaller core. PMID: 12153565
- biglycan showed a unique ability to organize collagen VI into extensive hexagonal-like networks over a time period of only a few minutes PMID: 12354766
- regulation of gene expression by transforming growth factor-beta requires MKK6-p38 mitogen-activated protein kinase signaling downstream of Smad signaling PMID: 12538652
- Biglycan may be involved in vascular smooth muscle growth & migration through cdk2- & p27-dependent pathways. Changes in its expression may affect arterial susceptibility to vascular injury, & may play a direct role in pathogenesis of vascular lesions. PMID: 15031262
顯示更多
收起更多
-
相關疾病:Meester-Loeys syndrome (MRLS); Spondyloepimetaphyseal dysplasia, X-linked (SEMDX)
-
亞細胞定位:Secreted, extracellular space, extracellular matrix.
-
蛋白家族:Small leucine-rich proteoglycan (SLRP) family, SLRP class I subfamily
-
組織特異性:Found in several connective tissues, especially in articular cartilages.
-
數據庫鏈接:
Most popular with customers
-
YWHAB Recombinant Monoclonal Antibody
Applications: ELISA, WB, IHC, IF, FC
Species Reactivity: Human, Mouse, Rat
-
Phospho-YAP1 (S127) Recombinant Monoclonal Antibody
Applications: ELISA, WB, IHC
Species Reactivity: Human
-
-
-
-
-
-
VDAC1 Recombinant Monoclonal Antibody
Applications: ELISA, WB, IHC
Species Reactivity: Human, Mouse, Rat